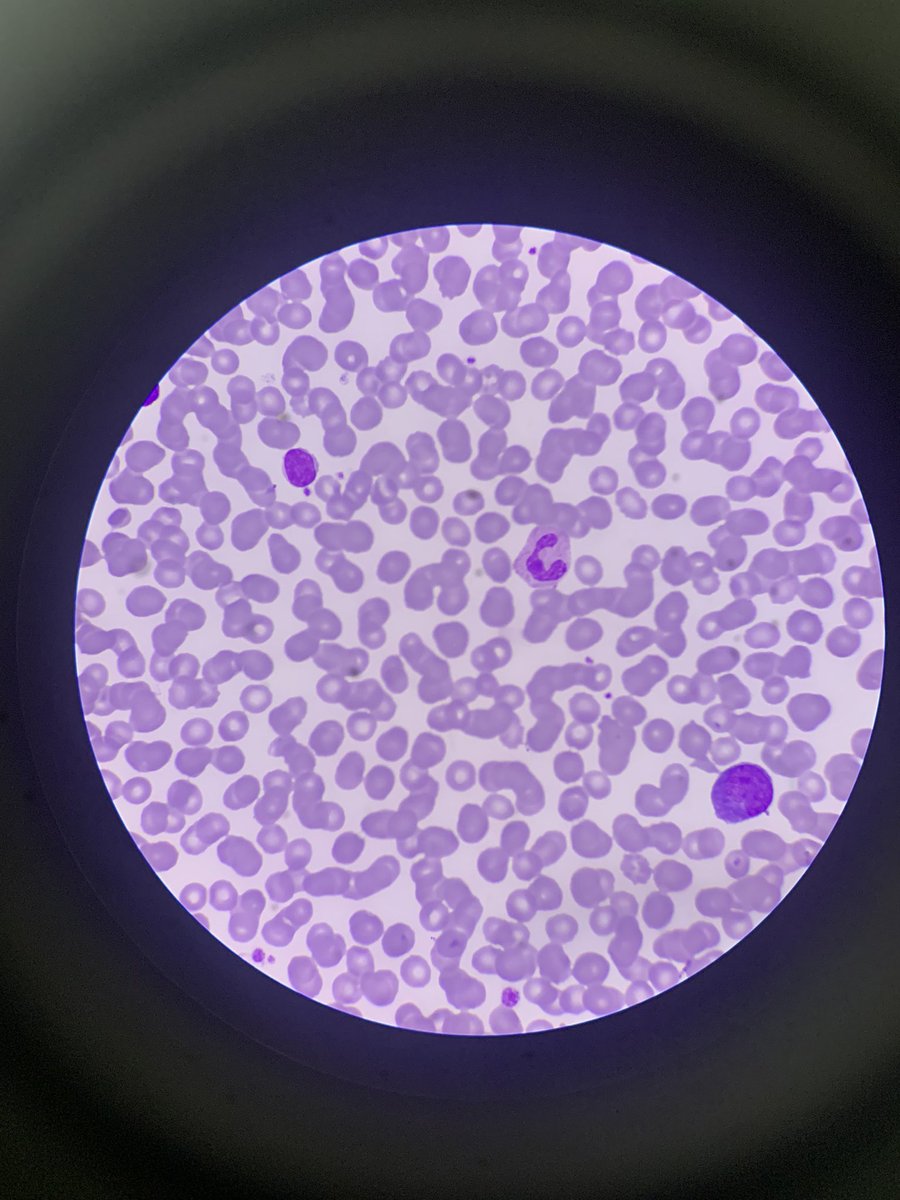
it’s pie ⸱̼ ᵕ ⸱̼ ᷅ ♡̷ tweet media

Angehefteter Tweet
it’s pie ⸱̼ ᵕ ⸱̼ ᷅ ♡̷
441 posts

it’s pie ⸱̼ ᵕ ⸱̼ ᷅ ♡̷
@studynomood
a 2nd year medical student at Chulalongkorn u. 🌇🧶🎹📸🥯 / study diary and lifestyles ´ސު`
Beigetreten Aralık 2022
24 Folgt1.1K Follower

ส่งต่อ Julia Ruffle Top ของmonacคั้บ✨
👗 size xs
✅ อปกไม้แขวน+garment cover
💸 ขาย 3000฿ รส. (shop3890฿)
#monac #monacstore #ส่งต่อmonac #ส่งต่อเสื้อผ้า #เสื้อผ้ามือสอง #โล๊ะตู้เสื้อผ้า #ส่งต่อเสื้อผ้ามือ2 #เสื้อผ้ามือ2 #เสื้อผ้ามือสองสภาพดี #ส่งต่อเสื้อผ้า




ส่งต่อเสื้อหนาว polo ralph lauren สีเหลืองค่าา 🌟 อก32-34
2300 baht
ไม่เคยใส่เลย ดูเพิ่มเติมทักdmค่ะ
#PoloRalphLauren

ไทย
it’s pie ⸱̼ ᵕ ⸱̼ ᷅ ♡̷ retweetet
it’s pie ⸱̼ ᵕ ⸱̼ ᷅ ♡̷ retweetet
it’s pie ⸱̼ ᵕ ⸱̼ ᷅ ♡̷ retweetet
it’s pie ⸱̼ ᵕ ⸱̼ ᷅ ♡̷ retweetet